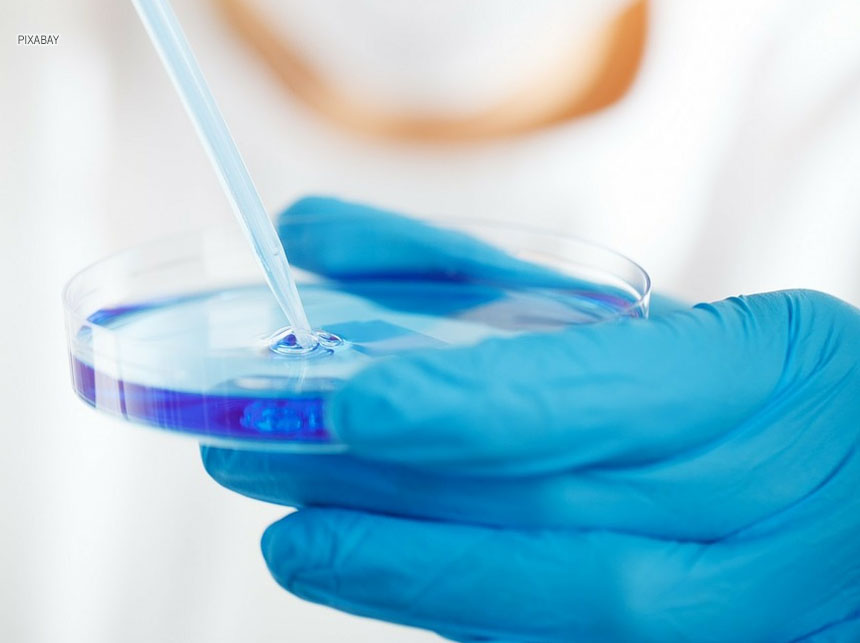
Iges-DF abre, nesta segunda (23), Fórum de Iniciação Científica

A semana começa com a demanda por vendedores ainda crescente nas agências do trabalhador. Das 1.190 vagas oferecidas nesta segunda-feira (23), 574 são para esses profissionais. A maioria pede que os candidatos tenham ensino médio completo. Os salários oferecidos ficam entre R$ 1.045 e R$ 2,5 mil.
Aos que têm nível superior, são 25 vagas para profissionais formados em telecomunicações, administração, enfermagem, nutrição, estatística e comunicação social. O melhor salário é oferecido para enfermeiros – R$ 4.750, mais benefícios. Para as outras áreas, as remunerações variam entre R$ 23,07 ao dia e R$ 2,5 mil mensais.
Seis profissões oferecem mais de 30 vagas: auxiliar de estoque (33), carpinteiro (32), consultor de vendas (49), gesseiro (33) e promotor de vendas (42). Os salários variam entre R$ 10 ao dia e R$ 1.738 mensais, mais benefícios.
Outras vagas menos frequentes que aparecem na tabela desta segunda-feira são para auxiliar de lavanderia (5), auxiliar de limpeza (3), caseiro (2), coletor de lixo (1), comprador (1), fiscal de prevenção de perdas (10) e vistoriador de alarmes (1). Nessas oportunidades, os salários variam entre R$ 1.045 e R$ 1.324.
Para os interessados, basta procurar uma das 15 agências do trabalhador em funcionamento no DF. Outra possibilidade é o aplicativo Sine Fácil, que, em virtude da pandemia de Covid-19, também disponibiliza o serviço.
Empreendedores que desejam buscar profissionais também podem utilizar os serviços das agências do trabalhador. Além do cadastro de vagas, é possível usar os espaços físicos para seleção dos candidatos encaminhados. Para isso, basta acessar o site da Secretaria de Trabalho e preencher o formulário na aba “Empregador”.